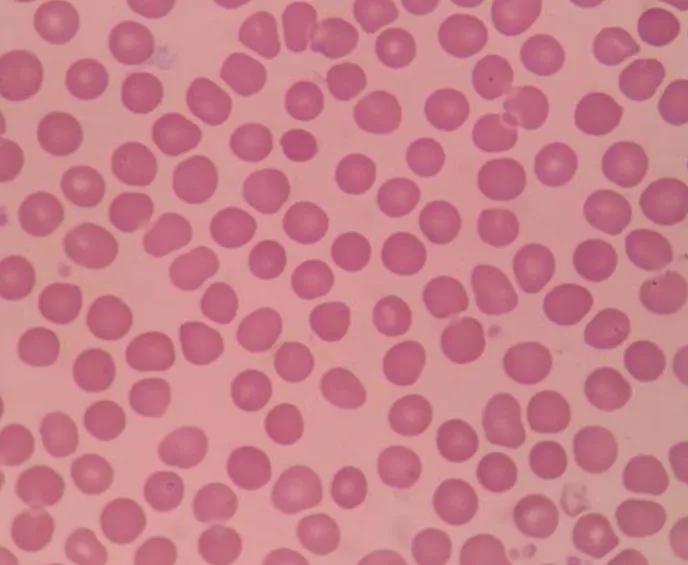

发布时间:2021-09-08
中医认为“春养肝,夏养心,秋养肺,冬养肾。”现在已过了立秋,正是开始养肺的时候。

肺为清虚之体而居高位,为五脏六腑之盖,开窍于鼻,外合皮毛,外感六淫之邪自口鼻皮毛而入,多先犯肺。肺叶娇嫩,不耐寒热,易被邪侵而发病,是人体最易“失守”的一道防线。

我们的肺部娇嫩,且与外界无时无刻都在进行氧气交换,最易受伤。想知道自己的肺功能是否正常,可按照以下4个方法进行自测。
点一根火柴尽力吹,如果距离嘴15厘米吹不灭,说明肺功能有问题;如果距离嘴5厘米吹不灭,说明肺功能很差。
用不紧不慢的速度一口气爬三楼,不感到明显的气急与胸闷,说明心肺功能良好。
深吸一口气后憋气,如果憋气达30秒,说明心肺功能良好。
原地跑一会,让脉搏增快到每分钟100~120次,停止活动后能在5~6分钟恢复正常,说明心肺功能良好。
如果通过了测试,那么恭喜你,说明你肺功能良好,应该保持。假如没有通过测试,也不用紧张,接下来狮子君就教大家秋季如何养肺,改善肺功能。
大气污染日益严重,人体吸入空气中的污染物,轻者可引起支气管炎、肺泡炎症,重者可引起中毒,甚至癌变。
因此,秋季应注意经常开窗通风换气,每天早晚选择空气清新的地方主动咳嗽,清除呼吸道及肺部的沉积物、污染物,减少肺部损害。

中医认为,肺与大肠相表里,便秘可诱发或加重慢性支气管肺炎等肺部疾病,又可诱发老年痴呆、癌症。
因此,通便既可以降肺气、泄浊阴,预防衰老、癌症,又可防治慢支、咳嗽等。平时应多喝水,多吃新鲜蔬菜和粗粮,多做腹部按摩。
笑口常开不仅是治疗百病的“良药”,也是促进体内器官年轻的“灵丹”,对肺尤其有益。
欢笑时或唱歌时,胸肌伸展,胸廓扩张,肺活量增加,可促进肺内气体的交换,从而消除疲劳,解除抑郁,抛开烦恼,有助于恢复精力与体力。

秋季每日至少要比其它季节多喝500毫升水,以保持肺与呼吸道的正常湿润度。
中医认为,燥为阳邪,易伤津损肺,耗伤肺阴,因此,秋季应注重食疗以润肺。
适当多吃酸的食物,还有百合、银耳、山药、秋梨、蜂蜜等有滋阴润肺作用的食物也可以多吃,养肺同时也有养肝的作用。同时,少吃辛味的葱、姜、蒜、韭、椒等辛辣食物,减少对肺部的刺激。


强健肺脏的最佳方法是适当的体育锻炼,可根据个人喜好的不同,身体的差异,选择合适的锻炼方法,如慢跑、散步、游泳、打太极拳等。可改善呼吸功能,增强心肺血液循环,增强心肺功能。


除以上6个方法外,坚持使用君康能阳光屋也能提升脏腑功能。君康能阳光屋萃取远红外线中5.6~15微米的阳光精华,这是人类赖以生存和维持健康必不可少的物质。

阳光精华在人体内通过“深层渗透-同频共振-内热效应”,活化全身60万亿个细胞,让身体由内而外地温热起来。

腹部是人体五脏六腑的集装箱,阳光屋的腹前板发射阳光精华温暖腹部,排出体内寒湿气,从而提升全身脏腑机能。

